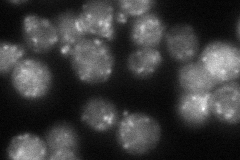
YGL200C
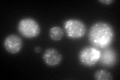
YGL200C

View description
Integral membrane component of endoplasmic reticulum-derived COPII-coated vesicles, which function in ER to Golgi transport
Localization:
Intensity:
Fold change:
Significance:
-
C’ GFP library in SD

punctate97.13 -
N' NOP1pr-GFP in SD

ER,punctate0 -
N' TEF2pr-mCherry in SD

punctate,vacuole79.2935 -
N' NATIVEpr-GFP in SD
punctate84.7087 -
N' TEF2pr-VC and Cyto-VN in SD

#N/A0 -
C’ GFP library in SD+DTT
punctate119.131.22No -
C’ GFP library in SD+H2O2

punctate, ERN/AN/ANo -
C’ GFP library in Starvation Media

punctate99.211.02No -
C’ GFP library on the background of Pup2-DaMP

punctate -
C’ GFP library on the background of CCT mutant

punctate94.94930.977414No
